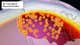

Arizona
Historic March Heat Wave For West, Plains, Including California, Arizona | Weather.com
Southwest Bakes Under Summerlike Heat
A historic heat wave is underway in the West that will also spread into parts of the Plains smashing all-time record highs for March, perhaps even April, and this will have staying power in the Southwest into next week.
(MAP: Temperatures Right Now)
March Records Already Set
Eleven cities in California and Arizona have already tied or set new March record highs.
For the first time in 96 years, Redwood City, California, hit 90 degrees in March on Monday. They did it again Tuesday, topping out at 93 degrees.
Other March records have been set in Santa Ana, California (100 degrees Tuesday) and tied in Flagstaff, Arizona (73 degrees Tuesday).

People flock to Baker Beach near the Golden Gate Bridge as a heat advisory was issued in San Francisco, California, on Monday, March 16, 2026.
(Tayfun Coskun/Anadolu via Getty Images)
Heat Wave Shifts To Higher Gear
There’s much more ahead in this heat wave.
The National Weather Service has issued extreme heat warnings and heat advisories in the Southwest. This is the first time a heat advisory has been issued in the Bay Area during in March.
(MORE: Heat Safety And Preparation)

It will not only intensify in the Southwest, but it will spread throughout much of the West into parts of the Plains later this week into the weekend.
While some cooler air will slide into the northern and central U.S. beginning Sunday, record heat will persist in the Southwest into at least the first half of next week.
How hot are we talking about? Think mid-summer heat as we’re turning the page officially to spring in mid-late March.
Triple-digit highs: The Desert Southwest, including Phoenix, Tucson, possibly as far north as Las Vegas, and parts of the L.A. Basin are forecast to see 100-degree-plus highs for multiple days. This weekend, a few of the hottest locations in the Southern Plains could also reach the century mark.
90s: California’s Central Valley, even parts of the Bay Area, will rise into the 90s for multiple days. This weekend, 90s are possible as far north as Nebraska, Colorado and Kansas. And that could reach as far east as Omaha and Kansas City.
(MAPS: 10-Day US Forecast Highs, Lows)

Historic Notables
Again, we’re not just talking about records set for a specific calendar day. This heat wave could set records for any March day in over 100 cities from California to Montana to Nebraska to Texas.
These are locations that could tie or set new all-time March heat records in this heat wave.
Prior to this, Phoenix, Arizona, had only hit 100 degrees once in March. They’re expected to see at least four, if not more, straight days of triple-digit highs in this heat wave. In an average year, they typically don’t reach 100 degrees until May 2.
Both Las Vegas and downtown Los Angeles have never hit 100 degrees in March. They have a low chance of doing that in this heat wave.
Kansas City hasn’t reached 90 degrees in March since 1910. They might do that this weekend. In parts of the Plains, highs this weekend could be as much as 40 degrees warmer than average.
Perhaps most impressive is some all-time March records for entire states could be in jeopardy. According to weather historian Christopher Burt, 10 states from Arizona and California to Wyoming to Oklahoma could threaten their all-time state March records, including:
- California: 107 at Mecca on March 21, 2004
- Arizona: 104 at Yuma on March 21, 2004
- Colorado: 96 at Holly on March 19, 1907
- Oklahoma: 104 at Frederick on March 27, 1971

But wait, there’s even more. Burt also noted the U.S. all-time March record of 108 degrees in Rio Grande City, Texas, is also in jeopardy.
If that city sounds a little familiar, this Deep South Texas reporting station recorded what may be the nation’s hottest winter temperature just over a month ago.
Put simply, this may be most significant, long-lived March heat wave the nation has experienced since the March 2012 heat wave rewrote the record books in the central U.S. and Canada.

Forecast Departures From Average High Temperatures
Why So Hot So Soon?
The reason for why this heatwave in particular has to do with the ridge of high pressure, also known as a heat dome, that is parked over the West.
This heat dome is record breaking for March, comparable in strength to ones we see in June. You can see the general position of the high pressure on the graphic below.

Record high pressure? Record temperatures. Temperatures we are seeing this week… in March... are comparable to what we should be seeing in summer.
This heat dome will eventually weaken and flatten a bit later next week.
Snow Drought, Climate Change
The warmest winter on record in much of the West has already left snowpack at its lowest levels in at least two decades from the Rockies of Colorado to the Oregon Cascades.
As the graph below shows, Colorado’s snowpack is least for any mid-March in the last 40 years, according to the USDA’s National Water and Climate Center.

This graph shows the water locked in Colorado’s snowpack each winter season, with 2025-26 shown by the black line. Areas in the light green shading can be considered “near average” for the state’s snowpack.
(NRCS/USDA)
After feet of snowfall in early February, California’s Sierra snowpack has since dwindled to only 42% of average for this time of year, according to the California Department of Water Resources. Melting snow in spring and summer typically supplies 30% of the state’s water. Fortunately, the state’s reservoirs are higher than average due to recent wet years.
This heat wave will further deplete the already paltry snowpack in the West. That could lead to an expansion of drought in the Southwest and higher fire danger early this summer before the summer monsoon kicks in, according to outlooks by NOAA and the National Interagency Fire Center.
And this heat wave appears to have climate change’s fingerprints on it.
According to an analysis by Climate Central, the magnitude of this heat wave by March standards has been made at least five times more likely by climate change.
Jonathan Erdman is a senior meteorologist at weather.com and has been covering national and international weather since 1996. Extreme and bizarre weather are his favorite topics. Reach out to him on Bluesky, X (formerly Twitter) and Facebook.
Arizona
Arizona Files Criminal Charges Against Kalshi Prediction Market Alleging an “Illegal Gambling Operation”
And Kalshi was having such a good week.
On Tuesday, Arizona Attorney General Kris Mayes filed criminal charges against KalshiEx LLC and Kalshi Trading LLC, the companies behind the Kalshi prediction market platform, for “operating an illegal gambling business in Arizona without a license,” and “for election wagering.” All told, the filing carries 20 charges.
“Kalshi may brand itself as a ‘prediction market,’ but what it’s actually doing is running an illegal gambling operation and taking bets on Arizona elections, both of which violate Arizona law,” Mayes said. “No company gets to decide for itself which laws to follow.”
Mayes alleges Kalshi “accepted bets from Arizona residents on a wide range of events in violation of Arizona law,” like professional and college sports — including prop bets — and whether the SAVE Act would become law. SAVE, or the Safeguard American Voter Eligibility Act, is a proposed federal law that would amend the National Voter Registration Act of 1993 to require “documentary proof of United States citizenship” to register to vote.
All told, the filing carries four counts of election wagering, including bets on the 2028 presidential race ($2 on J.D. Vance winning the big office), the 2026 Arizona gubernatorial race, the 2026 Arizona Republican gubernatorial primary and the 2026 Arizona Secretary of State race. Arizona law prohibits operating an unlicensed wagering business and separately bans betting on elections outright.
The bets specified for on each of the 20 counts ranged from $1-$30. Count 6 was a dollar bet on if Elon Musk would attend the Super Bowl. (He did not.)
“These state-court charges are seriously flawed. It’s gamesmanship,” a Kalshi spokesperson said in a statement provided to The Hollywood Reporter.
“Four days after Kalshi filed suit in federal court, these charges were filed to circumvent federal court and short-circuit the normal judicial process. They attempt to prevent federal courts from evaluating the case based on the merits — whether Kalshi is subject to exclusive federal jurisdiction,” the Kalshi statement continues. “These charges are meritless, and we look forward to fighting them in court.”
“Arizona will not be bullied into letting any company place itself above state law,” Mayes said.
At this point in the story, you’re probably wondering, what about Polymarket? Polymarket is an offshore platform and thus out of reach of U.S. regulators, but certainly not out of reach of bettors’ access.
More than $120 million in total was wagered on this past Sunday’s Oscars on Kalshi, a spokesperson told THR. The predictions markets on both Kalshi and Polymarket got 19 of 24 Academy Awards winners correct.
Arizona
Arizona Rattlers player accused of leaving dog in hot car for hours
GLENDALE, Ariz. – An Arizona Rattlers player is accused of leaving his dog inside a car for hours while he was at practice on Sunday evening.
What we know:
Officers responded to a report of a dog inside a vehicle in the parking lot of Desert Diamond Arena in Glendale just before 5:30 p.m. on March 15.
The dog was found inside the locked car, panting, with the windows closed with only a small crack, according to court documents.
The caller said they first saw the dog inside at around 3 p.m., and remained in the area until 6 p.m., where the dog remained inside with no owner present. They also told police they tried giving the animal water.
Dig deeper:
The owner of the car and dog, later identified as 24-year-old Patrick Jones, a linebacker for the Rattlers, arrived and initially told officers the vehicle wasn’t his but later admitted that it was.
Jones said he was staying at a hotel nearby and had nowhere else to keep the dog. While speaking to police, Jones got the dog out and told them they could take it “because he could not care for it,” court documents said.
What we don’t know:
The dog’s current health status has not been disclosed.
What’s next:
The dog was taken to an animal shelter. Jones was not arrested, but Glendale Police are filing animal cruelty charges.
Map of the incident location.
The Source: Glendale Police Department
Arizona
Arizona Cardinals free agency grades: DL Roy Lopez
The Cardinals added DL Roy Lopez in free agency. We grade the free agent addition for 2026.
The first week of NFL free agency is in the books. The Arizona Cardinals have been active, although they have not made any real significant moves like last offseason. It is time to start grading their initial moves.
We don’t know how they will actually work out, as the season is still months away, but based on need, fit and value, we can give initial grades.
Let’s look at defensive lineman Roy Lopez.
Grading the Cardinals’ signing of Roy Lopez
Grade: B-minus
Lopez returns to Arizona after a season in Detroit on a two-year, $10.5 million contract. He will presumably be the team’s starting nose tackle. He is not a spectacular player, but he is solid. He had career-highs in sacks (two) and quarterback hits (five) while playing in a rotational role for the Lions. He logged 425 defensive snaps.
He is a space eater. He is active. He doesn’t produce a lot, but he also didn’t cost much. He is a veteran, something badly needed in the Cardinals’ defensive line room after the release of Justin Jones and Bilal Nichols, and with the uncertain status of Calais Campbell.
He is another player who is not a bad signing. It’s decent signing.
Get more Cardinals and NFL coverage from Cards Wire’s Jess Root and others by listening to the latest on the Rise Up, See Red podcast. Subscribe on Spotify, YouTube or Apple podcasts.
-
Oklahoma1 week ago
OSSAA unveils Class 6A-2A basketball state tournament brackets, schedule
-
Oklahoma4 days agoFamily rallies around Oklahoma father after head-on crash
-
Michigan1 week agoOperation BBQ Relief helping with Southwest Michigan tornado recovery
-
Nebraska5 days agoWildfire forces immediate evacuation order for Farnam residents
-
Southeast1 week ago‘90 Day Fiancé’ alum’s boyfriend on trial for attempted murder over wild ‘Boca Bash’ accusations
-
Health1 week agoAncient herb known as ‘nature’s Valium’ touted for improving sleep and anxiety
-
Connecticut1 week agoExclusive | Ex-CBS anchor Josh Elliott back on Connecticut dating scene after ugly Liz Cho split
-
Georgia2 days agoHow ICE plans for a detention warehouse pushed a Georgia town to fight back | CNN Politics